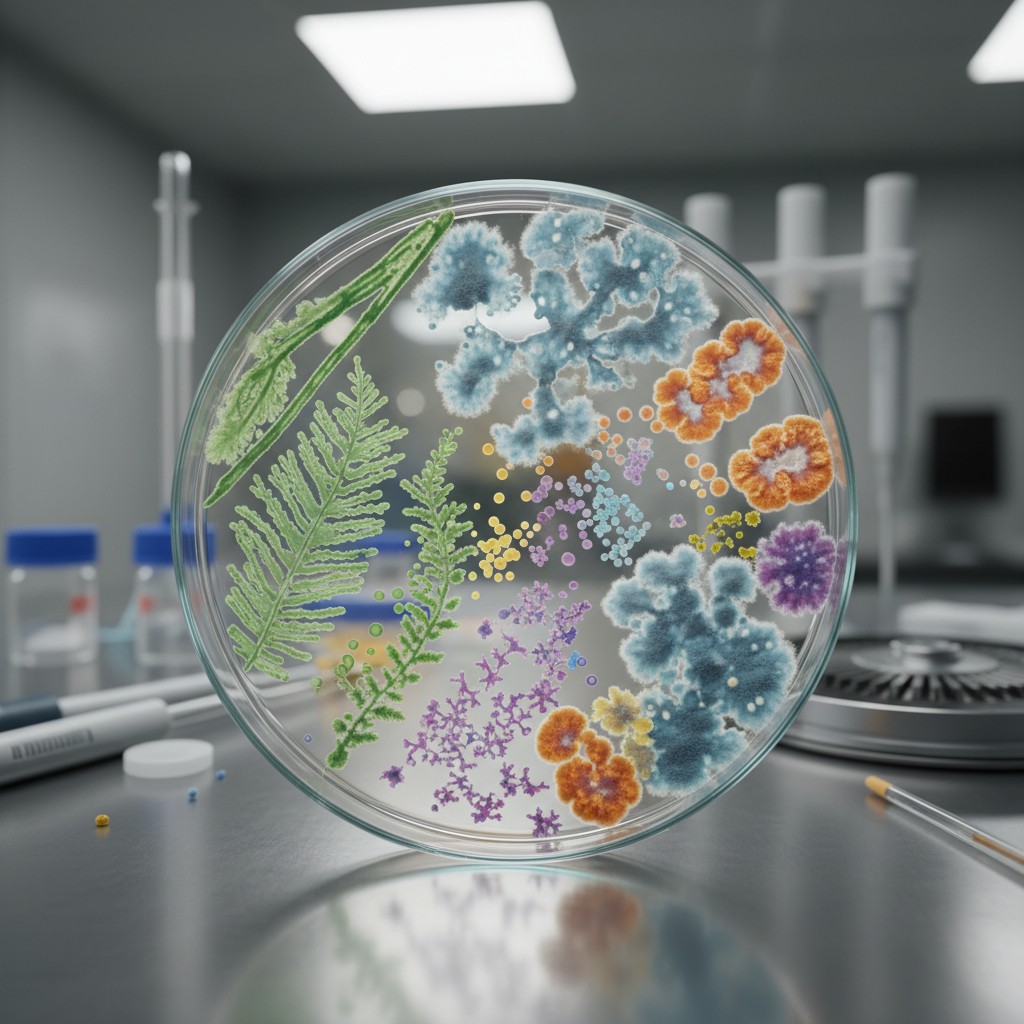
The microbiology lab. A sample petri dish, petri dishes in the background, and scientific equipment.

AI for Pathogen Genomics
We develop machine and deep learning models to automate virus classification at sub-species resolution, reconstruct complex phylogenies directly from genomic sequence data and connect genomic data to experimental and computational structure predictions.
Selection of publications in
AI for Pathogen Genomics:

Understanding infectious pathogen spread and evolution
Our research focuses on analyzing how infectious diseases like influenza, HIV, and emerging viruses propagate through populations, utilizing advanced models and modern as well as ancient genomic data to inform public health responses.
Selection of publications:
Phylodynamics of Infectious Diseases
My work focuses on infectious disease phylodynamics, exploring how pathogens evolve and spread through populations. I am actively involved in developing the BEAST 2 software for phylodynamic and evolutionary analyses, and I am involved in the global ‘Taming the BEAST’ workshops. My broader research addresses real-time outbreak analysis, ancient pathogen reconstruction, and advancing molecular epidemiology to inform public health response.
Selection of publications for phylodynamic methods:
